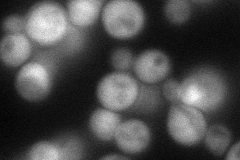

View description
Beta subunit of the CAAX farnesyltransferase (FTase) that prenylates the a-factor mating pheromone and Ras proteins; required for the membrane localization of Ras proteins and a-factor; homolog of the mammalian FTase beta subunit
Localization:
Intensity:
Fold change:
Significance:
-
C’ GFP library in SD

cytosol23.06 -
N' NOP1pr-GFP in SD
cytosol66.822 -
N' TEF2pr-mCherry in SD

missing0 -
N' NATIVEpr-GFP in SD

punctate18.2556 -
N' TEF2pr-VC and Cyto-VN in SD

below threshold29.7795 -
C’ GFP library in SD+DTT

cytosol24.281.05No -
C’ GFP library in SD+H2O2

cytosol24.711.07No -
C’ GFP library in Starvation Media

cytosol22.780.98No -
C’ GFP library on the background of Pup2-DaMP

cytosol -
C’ GFP library on the background of CCT mutant

cytosol26.1891.1354No
